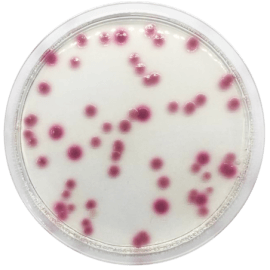
main product photo

Close
Klebsiella Chromogenic Agar Base 500 grams/bottle
SKU
CDL/2119
Brand
CONDALAB
Pre-order (Deliver in 8 to 12 weeks)
Klebsiella Chromogenic Agar Base is a selective medium for the isolation of Klebsiella. These Gram negative bacteria can cause different types of health-associated infections, including pneumonia, bloodstream infections, wounds or surgical infections and meningitis.
Klebsiella is usually found in human intestines (where it does not cause disease) and feces. Healthy people rarely suffer from Klebsiella infections, whereas in health centres they often occur in patients who are being treated. Patients requiring ventilation devices or intravenous catheters have a higher risk of contracting this type of infection.
Casein peptone is a source of nitrogen, vitamins and amino acids essential for growth. Sorbitol is the fermentable carbohydrate providing carbon and energy. The buffering capacity is provided by the disodium phosphate and monosodium phosphate. Sodium chloride maintains the osmotic equilibrium of the medium. Chromogenic mixture incorporated in the media is cleaved specifically by Klebsiella species to produce pink colonies. Tryptophan promotes the indole reaction when adding Kovac's reagent to detect the capability of the microorganism to cleave tryptophan. Agar is the solidifying agent.
Klebsiella Chromogenic Agar Base is a selective medium for the isolation of Klebsiella. These Gram negative bacteria can cause different types of health-associated infections, including pneumonia, bloodstream infections, wounds or surgical infections and meningitis.
Klebsiella is usually found in human intestines (where it does not cause disease) and feces. Healthy people rarely suffer from Klebsiella infections, whereas in health centres they often occur in patients who are being treated. Patients requiring ventilation devices or intravenous catheters have a higher risk of contracting this type of infection.
Casein peptone is a source of nitrogen, vitamins and amino acids essential for growth. Sorbitol is the fermentable carbohydrate providing carbon and energy. The buffering capacity is provided by the disodium phosphate and monosodium phosphate. Sodium chloride maintains the osmotic equilibrium of the medium. Chromogenic mixture incorporated in the media is cleaved specifically by Klebsiella species to produce pink colonies. Tryptophan promotes the indole reaction when adding Kovac's reagent to detect the capability of the microorganism to cleave tryptophan. Agar is the solidifying agent.
| Brand | CONDALAB |
|---|
Write Your Own Review

Validate your login